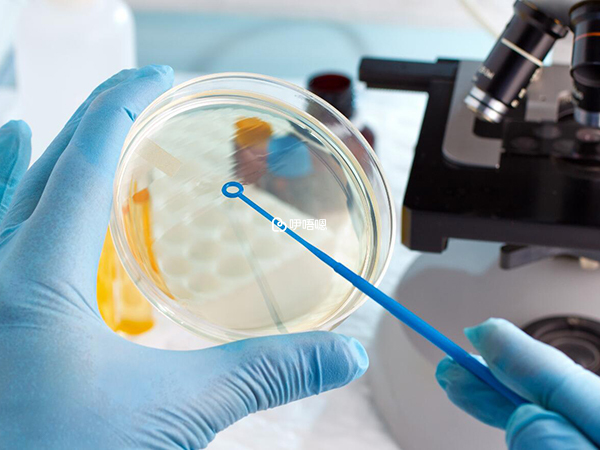

北京大學濱海醫院移植鮮囊胚14天好孕,附我的詳細開銷
我和老公是高中同學,談了10年戀愛,07年結婚。當時我已經29歲了,年紀不小,就想著快點生寶寶,老公家又是他一個兒子,也想為他們家傳宗接代。記得剛結婚沒有幾天,我拿衛生巾去廁所換,婆婆看見了就直接和我說,要我那個週期就著手懷小孩,我很聽話的答應。雖然我心裡也是這麼想,但是被別人要求的感覺就是不舒服,可能心裡的壓力從那個時候就種下了,反正那麼多年當時的情景總是歷歷在目。

子宮內膜異位試管經歷
當時以為懷孕很容易,我月經一向很準,也算了排卵期,但半年過去了還是沒有動靜。自己是學醫的,知道男方檢查比較容易,就催我老公去查精液了。結果是他的精子活力剛合格,而且還有前列腺炎,精索靜脈曲張,原體陽性。我當時心裡還小小松了口氣,起碼不是我的原因了。
反覆做輸卵管造影
我老公那時根本不想要孩子,隨便吃了幾天藥就不理了。過了幾個月我諮詢了一個婦科的朋友,她說精子活力已經足夠了,其它問題不用管。叫我做造影檢查一下輸卵管,我很奇怪,我從來沒有懷孕過,也沒有得過盆腔炎,應該沒有問題,但是安全起見還是在08年初做了,醫生說如果輸卵管不通造影的時候會很痛,我做的時候就沒有什麼感覺,只是難受而已。不出所料兩邊都是通的。
造影后三個月不能懷孕,我就老實的避孕了三個月,覺得應該沒有什麼問題了。可後面的大半年還是沒懷上,期間吃過中藥,BC排卵檢測,克米促排,還查了激素抗精子抗體,抗子宮內膜抗體。婦產科的朋友出的主意全都試了,沒有問題也沒有懷孕。
看過生殖專科醫生
2009年不得以開始去北京大學濱海醫院生殖專科看病。程式還得重來,BC監測,PCT,尿促促排,主任說老公的精子沒有問題,建議我做腹腔鏡探查。我真是暈倒,倒寧願自己有點什麼明顯的問題直接查出來就算了,要靠手術來檢查真是慘,一時接受不了這個結果,決定再試試其它方法。
看過中醫
聽說北京大學濱海醫院有個看不孕的專家是全國名老中醫,看好了挺多人,就興高采烈的去看。但是是要電話預約的,一天只看30個號,根本打不進去,打進的時候又已經掛滿了。好在朋友的朋友認識掛號的,就每個星期幫我掛一個,同時我還去做鍼灸,希望有幫助。

吃了兩個月的藥後那個醫生竟然和我說還是覺得是我輸卵管的問題,建議我做腹腔鏡。如果連中醫的主任都這麼說了,我真的就沒有理由不做了。09年8月份又回到生殖專科,馬上著手做腹腔鏡,結果出人意料,我竟然是子宮內膜異位症,因為內異的症狀我都沒有。
雖然查出只是一度,但是常規還是要吃藥半年才能懷孕,也有說法是腹腔鏡後要抓緊時間先懷孕。和老公商量了一下保險起見決定先吃藥,但是隻吃三個月,因為好怕吃了半年要還是懷不上又浪費時間。十月底三盒藥終於吃完了。
十一月初開始來例假,我終於又可以重新試孕了。那個時候知道了姐妹app,開始在上面認真潛水,學會了很多備孕知識,看見許多姐妹備孕成功的例子也讓自己大受鼓舞,於是信心滿滿的開始,我的例假一向很準,排卵期也很明顯,第一個月我覺得自己什麼好孕症狀都有了,plsz也有水印,我還以為自己這麼幸運手術後第一個月就好孕了,還沒有從喜悅中緩過勁YJ就來了,沒有懷孕。
那種心情估計不說姐妹們也可以理解,已經失望得有些習以為常了。後來才知道YJ前PLSZ是會有水印的,以後還是直接用ZZY算了。繼續量體溫,測PL,BC檢測,甚至促排。又過了四個月還是一無所獲。再去找我的主治醫師,他也說該做的都做過了沒轍了,讓我做試管,其實在做腹腔鏡之前我就想做試管了,只是程式上不允許。
現在終於走到這一步,在網上看見這麼多JM試管成功,還是讓我抱有大希望,身邊有個朋友也是十年不孕,腹腔鏡也查不出任何原因一做試管就懷上了雙雙,寶寶已經半歲了。其實三月還訂了去昆明的機票,想找陳院長看看,但是問問自己還能給等多久,最終還是放棄這個想法,一心做試管。3月18號,YJ來到,下決心開始試管,終於捱到了做試管,記錄一下試管過程,祝自己一次成功!
幾天的抽血加BC費用,取卵手術費,果納芬發育1800元,胚胎培養等一共6600元,冷凍費1500元。所有費用還要加上自己買了兩盒黃體酮栓劑大概1萬7千元。
陸陸續續開始取卵、移植
3月18號來月經,我終於開始我的試管歷程。3月19號,月經第2天,開始抽血檢查,之前有的檢查還能用就不用重新查了,我和老公的檢查費加起來1000元。
3月31號,月經第14天。繼續檢查,白帶,支原體,宮頸刮片,BC,加起來150元。上次的檢查除了地貧十八項沒出來其它的都正常了,和主治醫生說想4月進周開始降調,醫生答應了,讓我月經的21天診。心裡小高興了一下,終於可以正式開始了。

4月24號,YJ第八天,促排第六天,身體沒有不適,要不是自己時時提醒估計會忘記做試管這件事。4月25號,YJ第九天,促排第七天,BC左右卵巢共有10個大於10mm的泡泡,又開了一支果納芬注射筆。
4月27號,促排第九天,BC又長出兩個泡泡,但是右邊的普遍小一些,繼續打針;4月28號,停促排藥,晚上9點夜針10000單位HCG,定於30號取卵。
4月30號,早上7點40分,全麻下取卵15個,初定5月3日移植。
5月3號,複診,醫生告訴我15個卵子正常受精10個,給我做囊胚,5號由主任移植。
5月5號,10個胚胎培養出三個囊胚,有一個正在培養,移植兩個,凍一個,另一個等通知;5月6號,移植後第一天,肚子有點刺痛,打電話得知另一個囊胚沒有成功,失落。
5月9號,移植後第4天,一整天肚子隱隱作痛,有下墜感,像要來YJ了!5月10號,移植後第5天。早上發現臉上冒了三顆豆豆,噢,千萬別是YJ前兆啊。中午開始感覺腰痠,肚子咕咕叫。傍晚!plsz陽,試紙弱陽。我好像中獎了!
5月11號,移植後第六天,晨尿驗試紙有加深,一整天胃脹,肚子下墜,晚上看見內褲上有指甲蓋大小的褐色出血。擔心中……
5月13號,移植後第8天。試紙不負眾望,繼續加深。忍不住去抽血,hcg283,孕酮40。
我算成功了吧!5月14號,自己的生日。5月19號,第14天,hcg5331,孕酮﹥40。
基本資訊來自醫院官網或醫院內公示資訊或醫生本人提供,如有侵權,請按照平臺提供的渠道通知










